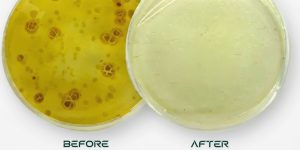

Specialized Sanitation Services
Comprehensive sanitation solutions throughout the Greater Houston Area. Our core services include professional trash can cleaning, full-service trash and linen chute services, compassionate bio-trauma and hoarding cleanup, and reliable trash valet solutions. We help residential, multi-family, and commercial properties eliminate odors, remove harmful bacteria, maintain code compliance, and keep communities clean, safe, and operating smoothly.
Trash Can Cleaning
Professional trash can cleaning across the Greater Houston Area, serving communities like The Woodlands, Humble, Pearland, Sugar Land, Katy, and Cypress. We cover more ground than any competitor, delivering reliable service across more neighborhoods and communities than anyone else in the region. We remove odors, grime, and harmful bacteria for a cleaner, healthier home.
Bio-Trauma Solutions
Compassionate, discreet bio-trauma cleanup throughout the Greater Houston Area. We handle hoarding cleanup, crime scene and trauma cleanup, unattended death cleanup, and biohazard remediation safely and respectfully—helping families and property owners restore spaces during difficult situations.
The Chute Company
Full-service trash, linen, and debris chute services throughout Texas, including chute cleaning, odor control, repairs, unclogging, inspections, temporary chute setups, and new installations. We help multi-family and commercial properties maintain sanitation standards and code compliance while keeping chute systems safe, functional, and running smoothly.

Bio-trauma Solutions

Sanitizing services

Chute Services
Our highly trained team uses advanced technology and certified decontamination protocols to deliver reliable and effective results. Whether you need deep sanitization, chute maintenance, or expert handling of biohazard situations, we provide high-quality solutions with a professional and responsible approach.
At Space City Sanitizers, we provide professional residential and commercial sanitization services designed to keep spaces safe, hygienic, and free from harmful pathogens. We specialize in trash can cleaning, hoarding cleanup, biotrauma cleanup, and comprehensive trash and linen chute services, including cleaning, repairs, and new construction.
Professional Sanitizing Divisions
Trash Can Cleaning Service
Why Do The Nasty Work Yourself? We Clean Dirty Garbage Bins
Space City Sanitizers provides professional, on-site trash can cleaning service In addition, our High Pressure Steam BlastTM service eliminates all odors and grime.
Express Service for Harris & Montgomery County.
Book online today and save 10% – leave the unpleasant work to us.
The Chute Company ~Trash Chute Cleaning & Service
Does Your Garbage Chute Stink?
We Are The Chute Company – Cleaning, Repairs, Compactors, Compliance Any Building – Any Height – Clogs, Service, Maintenance, Installation
Ask Us About Our Space Foam Antimicrobial Odor ControlTM Fully Compliant & Pre-Registered w/ All Major Property Asset Firms
Antiviral Disinfection Services
Professional Antimicrobial Services Cold & Flu Season Proof Your Spaces
Eliminate airborne and surface germs in your business or home with our professional Antimicrobial Fogging service – your space will be ready in 15 minutes.
Maintain a safe space with our suite of antiviral solutions for all markets. Fogging starting at 5¢ / sqft.
BioTrauma Solutions
PROFESSIONAL BIOTRAUMA REMEDIATION — RESTORING SAFETY & PEACE OF MIND
Our experts are standing by to handle the cleanup of hazard and trauma scenes. SCS BioTrauma Solutions specializes in hoarding cleanouts, death cleanup, and trauma scene restoration.
24/7 Available around the clock.
Why Choose Space City Sanitizers?
Experience and Expertise: We are trained and certified in trash can cleaning and sanitizing services to ensure hygiene, convenience, and reliability.
Reputation and Trust: The biodegradable and non-toxic cleaning agents we use are safe for your family as well as for the environment. Our safe practices have earned us positive reviews, a good reputation, and the trust of our customers.
Quality and Attention To Detail: Our team uses advanced equipment to remove dirt, bacteria, and bad odors from the trash cans.
Compassionate & Customer-focused service: We’re more than just a cleaning service—As a small business, we take the time to understand your needs and provide reliable, friendly service with a personal touch. Your satisfaction is our priority!
Here are some compelling reasons for choosing our trusted sanitization crew:
- Best Pricing For Value & Quality
- Effective Support & Scheduling
- Multi-Regional Experience
- Access to the A+ Team
- Full Range of Services
- Multi-Regional Customer Base
- Highest Customer Satisfaction
- Your #1 Original Sanitizers
What Our Customers Say About Us
Posted onKim OverallTrustindex verifies that the original source of the review is Google. Hard working and fast clean out crew. If you're a hoarder like me, or know someone who needs and wants help to get past the shame, call them. But!, put aside anything you must keep or else it's gone. They're that serious about helping to clean out a hoarder's hoard. They're careful with your keepsakes, too❤️ I really appreciate how much they accomplished in five hours. A great weight has been lifted off my soul. Thank you Space City Sanitizers!Posted onLaura DavisTrustindex verifies that the original source of the review is Google. Never thought my trash cans could smell so good!!Posted onKatherine MachTrustindex verifies that the original source of the review is Google. We have used Space City Sanitizers for 5+ years for our residential trash can cleaning and I love their service! They do a fantastic job cleaning our two cans on a quarterly basis, they are consistent, dependable, and super easy to work with. On our trash day our cans have to sit out on a super busy street and we end up having people dump their trash and pet waste in our can (😤) and so that means we have to have our can cleaned a lot more than normal. It makes us very thankful for space city sanitizers!Posted onPayton LynnTrustindex verifies that the original source of the review is Google. Great trash can cleaning service, would highly recommend!!Posted onPhillip NobleTrustindex verifies that the original source of the review is Google. My grandmother has developed severe dementia over the past few years, which has led to her home becoming overwhelmed with trash and unnecessary belongings. Into a point where we couldn’t spend time with her due to it being so packed and dirty! Thanks to space city sanitizers she can be in a peaceful clean safe space for the rest of her time here with us. It’s changed our families lives, and hers. The friendliness and care that they came in with can not be ignored! Thank you again for the great job and we will definitely be calling you for any cleaning needs in the future!!Posted onrosemary carterTrustindex verifies that the original source of the review is Google. The attentional to detail and communication from the office and the field was top notch. Communication was outstanding, from appointment reminders, to any questions we had.Posted onStéphanie ProvencherTrustindex verifies that the original source of the review is Google. I just started with this company and so far the experience has been great. They washed my trash can and did an amazing job, it was extremely dirty before and now it’s spotless and smells fresh. Customer service has been excellent; calling them is easy and they’re very responsive. I also have the valet service starting Monday, but based on everything so far, I highly recommend them. Five stars!Posted onDavid TusaTrustindex verifies that the original source of the review is Google. Awesome service! They show up on time and did a great job! Very professional ! Many thanks.